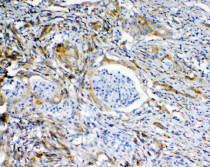

ARG42963
anti-MRP2 antibody
anti-MRP2 antibody for IHC-Formalin-fixed paraffin-embedded sections,Western blot and Human,Mouse
概述
| 产品描述 | Rabbit Polyclonal antibody recognizes MRP2 |
|---|---|
| 反应物种 | Hu, Ms |
| 应用 | IHC-P, WB |
| 宿主 | Rabbit |
| 克隆 | Polyclonal |
| 同位型 | IgG |
| 靶点名称 | MRP2 |
| 抗原物种 | Human |
| 抗原 | Synthetic peptide corresponding to a sequence of Human MRP2. (AIRHDCNFDKAMQFSEASFTWEHDSEATVRDVNLD) |
| 偶联标记 | Un-conjugated |
| 別名 | DJS; ATP-binding cassette sub-family C member 2; CMOAT; ABC30; cMRP; Canalicular multidrug resistance protein; MRP2; Canalicular multispecific organic anion transporter 1; Multidrug resistance-associated protein 2 |
应用说明
| 应用建议 |
|
||||||
|---|---|---|---|---|---|---|---|
| 应用说明 | IHC-P: Antigen Retrieval: Heat mediation was performed in Citrate buffer (pH 6.0) for 20 min. * The dilutions indicate recommended starting dilutions and the optimal dilutions or concentrations should be determined by the scientist. |
||||||
| 实际分子量 | ~ 210 kDa |
属性
| 形式 | Liquid |
|---|---|
| 纯化 | Affinity purification with immunogen. |
| 缓冲液 | 0.2% Na2HPO4, 0.9% NaCl, 0.05% Sodium azide and 4% Trehalose. |
| 抗菌剂 | 0.05% Sodium azide |
| 稳定剂 | 4% Trehalose |
| 浓度 | 0.5 mg/ml |
| 存放说明 | For continuous use, store undiluted antibody at 2-8°C for up to a week. For long-term storage, aliquot and store at -20°C or below. Storage in frost free freezers is not recommended. Avoid repeated freeze/thaw cycles. Suggest spin the vial prior to opening. The antibody solution should be gently mixed before use. |
| 注意事项 | For laboratory research only, not for drug, diagnostic or other use. |
生物信息
| 数据库连接 |
Swiss-port # Q8VI47 Mouse Canalicular multispecific organic anion transporter 1 Swiss-port # Q92887 Human Canalicular multispecific organic anion transporter 1 |
|---|---|
| 基因名称 | ABCC2 |
| 全名 | ATP-binding cassette, sub-family C (CFTR/MRP), member 2 |
| 背景介绍 | The protein encoded by this gene is a member of the superfamily of ATP-binding cassette (ABC) transporters. ABC proteins transport various molecules across extra- and intra-cellular membranes. ABC genes are divided into seven distinct subfamilies (ABC1, MDR/TAP, MRP, ALD, OABP, GCN20, White). This protein is a member of the MRP subfamily which is involved in multi-drug resistance. This protein is expressed in the canalicular (apical) part of the hepatocyte and functions in biliary transport. Substrates include anticancer drugs such as vinblastine; therefore, this protein appears to contribute to drug resistance in mammalian cells. Several different mutations in this gene have been observed in patients with Dubin-Johnson syndrome (DJS), an autosomal recessive disorder characterized by conjugated hyperbilirubinemia. [provided by RefSeq, Jul 2008] |
| 生物功能 | Mediates hepatobiliary excretion of numerous organic anions and conjugated organic anions such as methotrexate, 17beta-estradiol 17-glucosiduronic acid and leukotriene C4 (PubMed:11500505). Also transports sulfated bile salt such as taurolithocholate sulfate (PubMed:16332456). May function as a cellular cisplatin transporter. [UniProt] |
| 细胞定位 | Apical cell membrane; Multi-pass membrane protein. [UniProt] |
| 预测分子量 | 174 kDa |
检测图片 (7) Click the Picture to Zoom In
-
ARG42963 anti-MRP2 antibody IHC-P image
Immunohistochemistry: Paraffin-embedded Human liver cancer tissue. Antigen Retrieval: Heat mediation was performed in Citrate buffer (pH 6.0) for 20 min. The tissue section was blocked with 10% goat serum. The tissue section was then stained with ARG42963 anti-MRP2 antibody at 1 µg/ml dilution, overnight at 4°C.
-
ARG42963 anti-MRP2 antibody WB image
Western blot: 50 µg of sample under reducing conditions. Caco-2 whole cell lysate stained with ARG42963 anti-MRP2 antibody at 0.5 µg/ml dilution, overnight at 4°C.
-
ARG42963 anti-MRP2 antibody IHC-P image
Immunohistochemistry: Paraffin-embedded Human lung cancer tissue. Antigen Retrieval: Heat mediation was performed in Citrate buffer (pH 6.0) for 20 min. The tissue section was blocked with 10% goat serum. The tissue section was then stained with ARG42963 anti-MRP2 antibody at 1 µg/ml dilution, overnight at 4°C.
-
ARG42963 anti-MRP2 antibody IHC-P image
Immunohistochemistry: Paraffin-embedded Human rectal cancer tissue. Antigen Retrieval: Heat mediation was performed in Citrate buffer (pH 6.0) for 20 min. The tissue section was blocked with 10% goat serum. The tissue section was then stained with ARG42963 anti-MRP2 antibody at 1 µg/ml dilution, overnight at 4°C.
-
ARG42963 anti-MRP2 antibody IHC-P image
Immunohistochemistry: Paraffin-embedded Mouse kidney tissue. Antigen Retrieval: Heat mediation was performed in Citrate buffer (pH 6.0) for 20 min. The tissue section was blocked with 10% goat serum. The tissue section was then stained with ARG42963 anti-MRP2 antibody at 1 µg/ml dilution, overnight at 4°C.
-
ARG42963 anti-MRP2 antibody IHC-P image
Immunohistochemistry: Paraffin-embedded Human mammary cancer tissue. Antigen Retrieval: Heat mediation was performed in Citrate buffer (pH 6.0) for 20 min. The tissue section was blocked with 10% goat serum. The tissue section was then stained with ARG42963 anti-MRP2 antibody at 1 µg/ml dilution, overnight at 4°C.
-
ARG42963 anti-MRP2 antibody IHC-P image
Immunohistochemistry: Paraffin-embedded Mouse liver tissue. Antigen Retrieval: Heat mediation was performed in Citrate buffer (pH 6.0) for 20 min. The tissue section was blocked with 10% goat serum. The tissue section was then stained with ARG42963 anti-MRP2 antibody at 1 µg/ml dilution, overnight at 4°C.